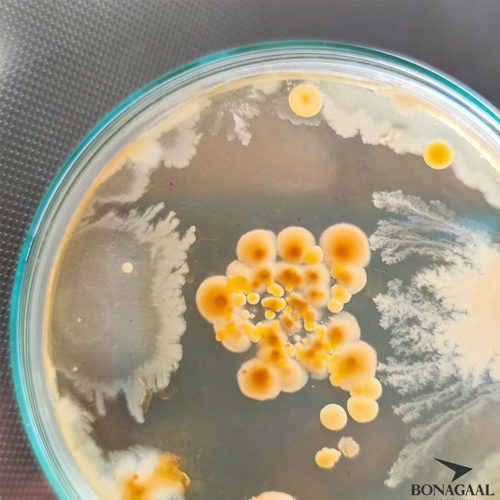
about

5 szokás, amellyel ártasz az immunrendszerednek
Mindennapi szokásaink nagy befolyással vannak immunrendszerünkre, de mik is azok a szokások, amik károsan hathatnak rá és érdemes lenne elkerülni őket?
ElolvasomÜdvözlünk a VITANOON-nál
A VITANOON család olyan emberekből áll, akiknek fontosak a hagyományos értékek, mint például a család és a minőségi időtöltés szeretteinkkel. Célunk, hogy minden ember számára lehetőséget biztosítsunk, hogy a lehető legteljesebb életet élhesse, hiszen a világon a legfontosabb kincs az egészség és az idő. Ez a két fogalom az élet során szorosan összefonódik, ugyanis a minőségi időtöltés elengedhetetlen hozzávalója a vitalitás és az egészség, mi ehhez szeretnénk egy utat mutatni.
Hitvallásunk szerint már az ősi időkben megtalálhatóak voltak a természetben a gyógymódok minden betegségre, és hiszünk abban, hogy a természet adta anyagokkal és vitaminokkal való támogatás szervezetünknek a legjobb módja az életerő megőrzésének.
Csapatunk minden tagjának más fontos a megfelelő étrendkiegészítő kiválasztásakor, mind mások vagyunk más-más szükségletekkel és életvitellel. Ennek köszönhetően mi olyan táplálékkiegészítőket állítottunk össze, melyek minden ember számára hasznosak lehetnek.
Az egészség és a jólét központi szerepet játszik mindannyiunk életében.
20 éve dinamikusan fejlődő cégcsoport legújabb vállalata vagyunk.

Ezt olyan étrend-kiegészítők fogyasztásával érhetjük el, melyek nem a "milligramm versenyben" kiemelkedőek, hanem komponenseit egy olyan szakmai stáb állította össze, akik több évtizedes tapasztalattal rendelkeznek az egészségügy, gyógyszerkutatás és termékfejlesztés területén. Minőségi alapanyagokat tartalmaznak az emberi szervezet számára szükséges mennyiségben, különböző mesterséges hordozók és adalékanyagok nélkül.
Termékfejlesztéskor a fenti szempontokat tartottuk legfontosabbnak és ebben csapatunk egyik tagja sem tűrt kompromisszumot.
Összetevőinket úgy válogattuk össze, hogy azok a lehető legjobb szinergizmust érjék el, immunrendszerünket a leghatékonyabban legyenek képesek támogatni.
Megnézem a termékeketA táplálék kiegészítők területén 30 éves tapasztalattal rendelkezünk
Folyamatosan nyomon követjük a legújabb trendeket és technológiákat

Rendszeresen értesítünk speciális ajánlatainkról, új termékeinkről és érdekes új tartalmakról a blogunkban.
19 000 Ft felett ingyen szállítunk az ország egész területére
Ügyfélszolgálatunkat a hét minden napján elérheted online
Biztonságos csatornán keresztül kifizetheted rendelésedet online